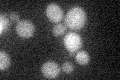
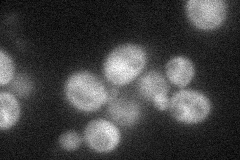
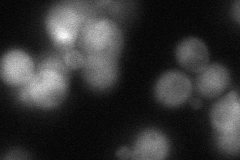
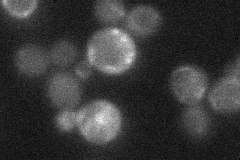

View description
GDP/GTP exchange protein (GEP) for Rho1p; mutations are synthetically lethal with mutations in rom2, which also encodes a GEP
Localization:
Intensity:
Fold change:
Significance:
-
C’ GFP library in SD
below threshold17.16 -
N' NOP1pr-GFP in SD
cytosol38.7481 -
N' TEF2pr-mCherry in SD
cytosol272.942 -
N' NATIVEpr-GFP in SD
punctate22.9926 -
N' TEF2pr-VC and Cyto-VN in SD

cytosol31.363 -
C’ GFP library in SD+DTT

cytosol17.881.04No -
C’ GFP library in SD+H2O2

cytosol21.311.24No -
C’ GFP library in Starvation Media

cytosol17.531.02No -
C’ GFP library on the background of Pup2-DaMP

below threshold -
C’ GFP library on the background of CCT mutant

below threshold19.53461.13789No
